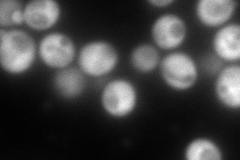
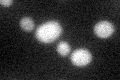

View description
NADP(+)-dependent glutamate dehydrogenase, synthesizes glutamate from ammonia and alpha-ketoglutarate; rate of alpha-ketoglutarate utilization differs from Gdh1p; expression regulated by nitrogen and carbon sources
Localization:
Intensity:
Fold change:
Significance:
-
C’ GFP library in SD

cytosol21.58 -
N' NOP1pr-GFP in SD
cytosol0 -
N' TEF2pr-mCherry in SD

cytosol373.984 -
N' NATIVEpr-GFP in SD

below threshold26.3252 -
N' TEF2pr-VC and Cyto-VN in SD

#N/A0 -
C’ GFP library in SD+DTT
cytosol21.190.98No -
C’ GFP library in SD+H2O2

cytosol21.891.01No -
C’ GFP library in Starvation Media

cytosol34.521.59No -
C’ GFP library on the background of Pup2-DaMP

cytosol -
C’ GFP library on the background of CCT mutant

cytosol25.41971.17767No
